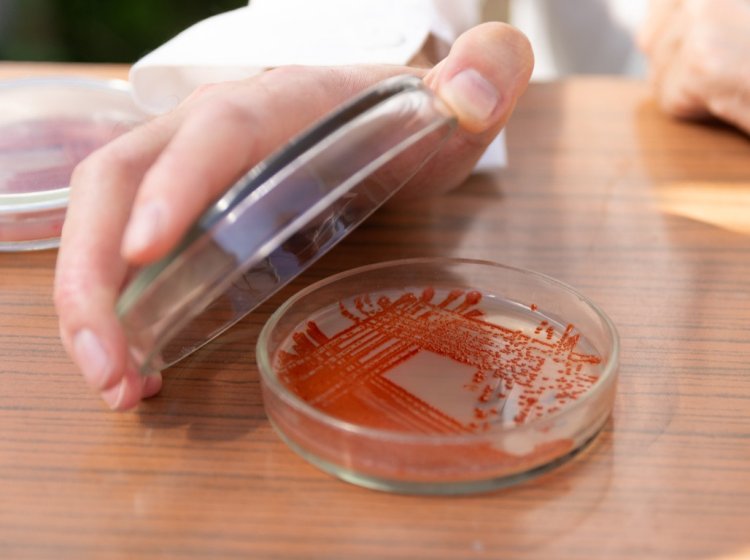
Образцы бактерий, использованных учеными УрФУ в качестве основы биопрепарата для защиты сельскохозяйственных культур от стресса. Фото: Владимир Мартьянов / УрФУ

Испокон веков человек стремится обратить силы природы себе во благо. Одна из них, незаметная, но мощная и окружающая нас повсюду, — бактерии. Их вселенная необъятна, а возможности по-настоящему многогранны. Сегодня ученые находят микроорганизмам самые разные полезные применения: от борьбы с городской пылью до получения ценных медицинских материалов. О проектах российских исследователей, «приручивших» бактерии для задач сельского хозяйства, медицины, экологии и даже реставрации скульптур, — новая статья «Научной России».
В городах и шахтах: на страже чистоты
Обширная сфера применения бактерий — экология, оздоровление окружающей среды. Интересный проект в этом направлении представили исследователи из Новосибирского государственного технического университета НЭТИ: ученые создали жидкий пылеподавитель, в котором микроорганизмы играют важную роль. Полученную жидкость можно использовать в черте города, здесь она поможет бороться с дорожной и строительной пылью. В этом случае создатели предлагают добавлять пылеподавитель в баки поливальных машин.
Созданный в НГТУ НЭТИ жидкий пылеподавитель с бактериями в составе предотвращает рассеивание частиц пыли в воздухе.
Фото: Вероника Жарковская / пресс-служба НГТУ НЭТИ
О разработке корреспонденту «Научной России» рассказала руководитель проекта «Биогели для санитарно-гигиенического профиля» в рамках программы «Приоритет-2030» младший научный сотрудник Центра технологического превосходства НГТУ НЭТИ, аспирант Анна Александровна Пронченко: «Пылеподавитель состоит из органического биополимера и распространенных почвенных микроорганизмов. Так как наш состав при распылении попадает на землю, необходимо, чтобы он не только работал по прямому назначению, но и давал второстепенный положительный эффект — а именно, выступал в роли удобрения».
Младший научный сотрудник Центра технологического превосходства НГТУ НЭТИ, аспирант Анна Александровна Пронченко.
Фото: из личного архива А.А. Пронченко
Механизм действия состава прост. Полимер в составе пылеподавителя связывает частицы пыли. Она покрывается тонкой пленкой, поддерживаемой бактериями, и собирается в комки, переставая рассеиваться в воздухе. Далее прибитую к земле пыль необходимо собрать с помощью обычных средств. Интересно, что микроорганизмы также способны частично поедать загрязняющие частицы.
«Бактерии в составе жидкости действительно могут поглощать пыль, но делают это постепенно и в небольших масштабах. Поэтому, чтобы увидеть результат работы микроорганизмов невооруженным глазом, потребуется довольно много времени. Важнее то, что они сохраняют и удерживают пленку, покрывающую пыль, — пояснила А.А. Пронченко. — После проведения такой обработки в городской среде желательно собрать пыль вместе с пленкой с помощью подметальной машины или щетки и утилизировать. Или, как вариант, использовать в качестве удобрения на близлежащей придорожной территории».
Во время испытаний состав показал способность эффективно бороться с пылью, превзойдя привычную воду, которая останавливает загрязняющие частицы только до момента испарения.
«Первые испытания проводились в лабораторных условиях. Мы пытались по максимуму воспроизвести различные погодные условия: имитировали дождь, ветер (в аэротрубе), заморозку и оттаивание (от −40 °C до +30 °C). Во всех случаях эффективность пылеподавителя сохранялась, влияние среды было минимальным. Свойства пленки оставались неизменными, — отметила А.А. Пронченко. — Подтвердив, что состав работает, мы договорились о проведении испытаний в Кировском районе в условиях реальной городской среды, а также проверили эффективность состава при распылении с помощью дронов. Тестирование дало положительные результаты. К настоящему времени продукт уже зарегистрирован, имеет паспорт безопасности и полностью готов приносить пользу».
Пылеподавитель успешно прошел испытания в городской среде.
Фото: Александр Непомнящих / пресс-служба НГТУ НЭТИ
Получившийся пылеподавитель нетоксичен и стоит в десять раз меньше зарубежных аналогов, поскольку производится из местного сырья. Помимо городов, разработка пригодится в шахтах (именно для них жидкость создавалась изначально), на производствах, в сельском хозяйстве, на складах с сыпучими материалами. Востребован новый состав и на железных дорогах: при перевозке угля поездами в воздух выбрасываются большие объемы угольной пыли.
«В настоящее время мы по запросу заказчика испытываем наш состав на других загрязнителях, помимо пыли и угля, — например, на строительных смесях», — добавила А.А. Пронченко.
Исследователи также хотят разработать версию пылеподавителя для северных территорий: такая жидкость должна будет эффективно работать при температуре −50 °C. В этих регионах средство будет особенно актуально как раз для железных дорог, где на очистку вагонов тратятся огромные ресурсы.
Микроскопические реставраторы
Необычный способ применения бактерий представили исследователи из Архитектурно-строительного института Южно-Уральского государственного университета. В 2025 г. ученые впервые в России использовали микроорганизмы, чтобы восстановить скульптуру — памятник матери, защищающей детей в тяжелые годы войны, установленный в городе Боровске.
Ранее монумент нужно было ремонтировать каждые два года из-за особенностей конструкции. Но в этот раз для реставрации было решено использовать самовосстанавливающийся бетон, разработанный исследователями по просьбе партнеров из Центра компетенций городской среды. Отличие нового материала заключается в живом компоненте — сенной палочке, для которой в бетон добавлен лактат кальция. Поедая эту органическую пищу, бактерия выделяет особый минерал — он заполняет микротрещины, возникающие в памятнике с течением времени, и не дает воде и воздуху проникать внутрь и усиливать разрушение памятника.
Реставрация скульптур — еще один примечательный способ применения бактерий, продемонстрированный учеными ЮУрГУ.
Фото: wirestock / фотобанк Freepik (представлено в иллюстративных целях)
Ученые полагают, что инновация поможет лучше сохранять скульптуру, поскольку бактерии будут оперативно «заклеивать» микроскопические повреждения, не позволяя им расшириться до серьезных трещин. Исследование показало, что новый бетон самовосстанавливается в пять раз быстрее обычного: чтобы зарастить трещины, ему требуется не 50, а всего десять циклов естественного намокания и высушивания. Кроме того, строительный материал, выделяемый сенной палочкой, повышает плотность бетона, делая его прочнее.
Ученые продолжают наблюдать за состоянием памятника. Вопреки ожиданиям, возникающим при работе с материалами обычного состава, инновационный бетон не показал ни одной микротрещины в течение первой недели после реставрации. А проведенные позднее ультразвуковые исследования выявили, что плотность отреставрированных участков памятника постепенно растет. Таким образом, бактерии успешно справляются с заботой о скульптуре.
Разработка исследователей из ЮУрГУ пригодится и для других задач: например, строительства бетонных дорог, а также ремонта и реставрации зданий.
Группа поддержки для культурных растений
Бактерии — неотъемлемая часть живого мира нашей планеты, и порой от них зависит успешное выживание других обитателей биосферы. Яркий пример — бактерии, стимулирующие рост растений (Plant Growth-Promoting Bacteria, PGP). Именно такие микроорганизмы легли в основу биопрепарата для поддержки сельскохозяйственных культур, созданного учеными Уральского федерального университета. Деталями проекта с корреспондентом «Научной России» поделилась руководитель проекта доцент кафедры экспериментальной биологии и биотехнологий УрФУ, кандидат биологических наук Анастасия Сергеевна Тугбаева.
«Идея исследования выросла из научного направления нашей кафедры — изучения устойчивости растений к абиотическим стрессовым факторам, — рассказала А.С. Тугбаева. — Традиционно мы уделяли большое внимание воздействию тяжелых металлов, поскольку именно этот тип загрязнения характерен для Уральского региона. Однако не менее серьезную проблему для агроэкосистем представляет засоление почв, существенно снижающее урожайность. Поэтому я решила развить новое направление исследований, связанное с механизмами устойчивости растений к засолению».
Доцент кафедры экспериментальной биологии и биотехнологий УрФУ, кандидат биологических наук Анастасия Сергеевна Тугбаева.
Фото: Анастасия Мавренкова / УрФУ
Засоление — глобальная проблема сельского хозяйства. Она особенно остра в засушливых регионах — например, в Австралии, Индии, Казахстане. В нашей стране с ней сталкиваются жители юга Сибири, Калмыкии и Ставрополья. По оценкам Продовольственной и сельскохозяйственной организации ООН, из-за засоления почв сельскохозяйственная отрасль ежегодно теряет около $27 млрд.
За основу биопрепарата уральские ученые взяли бактерии, выделенные из ризосферы* галофитов — растений, произрастающих на сильно засоленных почвах, например на морских берегах и солончаках. Так, в фокус исследования попала лебеда простертая, растущая на соленом озере Атавлы в Курганской области.
«Во время экспедиции мы посетили семь озер Челябинской и Курганской области, в том числе озеро Атавлы. Озера подбирались по уровню и типу минерализации, — объяснила А.С. Тугбаева. — Мы выявляли доминирующие виды в сообществах галофитов на этих территориях и подвергали их дальнейшему анализу. В настоящее время в рамках проекта изучаются восемь видов галофитных растений, что позволяет сравнивать разные стратегии адаптации к засолению».
Созданное учеными УрФУ бактериальное удобрение прошло первые лабораторные испытания на пшенице и ячмене.
Фото: Владимир Мартьянов / УрФУ
Чтобы выяснить, какие бактерии обитают в ризосфере галофитов, и оценить их возможности, биологи использовали передовые методы генетических исследований. Для определения состава микробных сообществ как единого целого применялся метагеномный анализ, а для точного установления вида отдельных бактерий — молекулярно-генетический.
В результате исследователи отобрали несколько ценных штаммов микроорганизмов. А.С. Тугбаева отмечает, что они выделяют стимуляторы роста растений — фитогормоны, улучшают минеральное питание своих зеленых соседей путем повышения усвояемости азота и фосфатов в почве и делают растения устойчивее к засолению. Отобранные микроорганизмы культивировались в лабораторных условиях, после чего на их основе создали биопрепарат.
«Мы готовим биопрепарат в несколько этапов. Сначала клетки бактерий выращиваются в жидкой питательной среде, — пояснила А.С. Тугбаева. — Затем мы осаждаем их с помощью центрифугирования, удаляем культуральную жидкость и доводим до нужной концентрации, используя физраствор. В результате получается суспензия клеток бактерий, которой семена обрабатываются перед посевом».
Бактериальное удобрение прошло первые лабораторные испытания на пшенице и ячмене, высаженных на почвах, насыщенных хлоридами и сульфатами. Результаты показали, что выбранные бактерии потенциально пригодны для поддержки культурных растений, неприспособленных к засолению: обработанные злаки росли быстрее и лучше справлялись со стрессом, чем их собратья, вынужденные выживать «своими силами».
Сейчас исследователи оценивают влияние на рост злаков десяти штаммов бактерий.
Фото: Владимир Мартьянов / УрФУ
«В настоящий момент мы оцениваем влияние десяти штаммов бактерий на рост злаковых культур в испытаниях двух видов. В первом случае тестируется воздействие штаммов на растения на этапе прорастания семян и развития проростков злаков. Во втором случае препараты испытываются в длительных экспериментах: растения культивируются в почве в вегетационных сосудах до этапа созревания семян, — описала А.С. Тугбаева. — Мы уже отобрали несколько штаммов, усиливающих развитие корневой системы и приводящих к увеличению массы растений в условиях засоления. Кроме того, при использовании биопрепарата был выявлен прирост урожайности пшеницы и ячменя в условиях умеренного сульфатного засоления».
Разработки ведутся при поддержке Российского научного фонда (проект № 24–76–10062) и Министерства науки и высшего образования России. Впереди у исследователей еще немало работы.
«Мы планируем протестировать влияние биопрепарата на рост растений во время полевых испытаний, — заключила А.С. Тугбаева. — В перспективе препараты на основе бактерий можно использовать для обработки сельскохозяйственных и декоративных растений, но перед этим нужно подобрать “рабочую дозу” микроорганизмов и окончательно подтвердить эффективность использования биопрепарата на новых культурах».
*Ризосфера — слой почвы толщиной 2–3 мм, окружающий корни растения и сильно насыщенный микроорганизмами.
Источник определения: Большая советская энциклопедия: В 30 т. 3-е изд. М.: Советская энциклопедия, 1969–1986 (статья размещена на сайте Вологодской областной универсальной научной библиотеки).
Живые фабрики наноструктур
Производители ценных магнитных наноструктур — еще одна примечательная роль бактерий, обнаруженная российскими учеными. В команду исследователей вошли специалисты из Центра коллективного пользования «Сибирский кольцевой источник фотонов» (СКИФ), Томского государственного университета, Национального исследовательского центра «Курчатовский институт» и трех организаций Сибирского отделения РАН — Института физики, Института ядерной физики и Института химии твердого тела и механохимии. Работы проводились при поддержке Российского научного фонда. Для анализа использовались источники синхротронного излучения.
Штамм микроорганизмов Desulfovibrio sp. A2 производит биосовместимые наноструктуры, в перспективе способные стать ценным инструментом для гипертермической терапии опухолей.
Источник изображения: brgfx / фотобанк Freepik
Специалисты изучили два штамма микроорганизмов, обитающих в стоках промышленных предприятий. Один из них — Desulfovibrio sp. A2. Исследования показали, что эти бактерии формируют биосовместимые наноструктуры, состоящие сразу из нескольких веществ: железосодержащего минерала вивианита, кристаллических фаз серы и наночастиц ферригидрита. Подобные микроскопические образования способны принести пользу в медицине: выяснилось, что их магнитными свойствами можно точно управлять, незначительно изменяя их локальную атомную структуру. Благодаря этому такие наноструктуры могут пригодиться в целевой доставке препаратов или гипертермической терапии опухолей (то есть их уничтожении с помощью повышенной температуры). При этом по сравнению с привычными химическими методами получение наноматериалов с помощью бактерий стоит дешевле и не требует использования токсичных веществ.
Второй штамм, изученный научной командой, — Desulfosporosinus sp. OL — оказался перспективным для использования в области экологии. Эти бактерии и производимые ими магнитные наночастицы могут помочь эффективно извлекать из сточных вод и промышленных отходов фосфор — ценное сырье для производства литиевых батарей, катализаторов и удобрений.
Разлагая, созидать
Задействовать бактерии для утилизации пищевых отходов и одновременно создания экономичных скаффолдов для восстановления костей удалось исследователям из Сибирского федерального университета. Такие биосовместимые каркасы используют при тяжелых переломах: их устанавливают на место утраченного фрагмента кости, чтобы на них постепенно нарастали новые клетки костной ткани.
За основу скаффолдов ученые взяли биополимеры полигидроксиалканоаты (ПГА), для получения которых использовались специальные бактерии. Чтобы оригинальные «работники» производили нужные соединения, их нужно подкармливать любыми углеродсодержащими органическими отходами. В частности, исследователи предлагают использовать в качестве пищи для бактерий отработанный фритюрный жир и отходы переработки рыбы. Это весьма выгодное решение, поскольку обычно их утилизация требует больших вложений.
Ученые из СФУ применяют специальные бактерии для получения биополимеров, из которых в дальнейшем печатают на 3D-принтере скаффолды для восстановления костей.
Фото: freepik / фотобанк Freepik
Для производства костных скаффолдов в России чаще всего используют дорогие импортные материалы. В то же время использование бактерий и доступных пищевых отходов снижает стоимость изготовления имплантатов примерно вдвое. А качество таких каркасов, как отмечают разработчики, соответствует зарубежным аналогам.
Из ПГА, произведенных бактериями, исследователи изготавливают биополимерную нить.
«В отличие от большинства компаний, которые закупают готовые филаменты зарубежного производства, мы самостоятельно производим экструзионную нить, что позволяет варьировать ее свойства под различные потребности», — приводятся на сайте СФУ слова ассистента базовой кафедры биотехнологии и кафедры медицинской биологии Алексея Евгеньевича Дудаева.
Полученная нить используется для печати нужной конструкции на 3D-принтере. Скаффолды индивидуальны: модель будущего имплантата создается на основе данных, собранных в результате компьютерной томографии места повреждения.
Ученые изготовили разные варианты каркасов: с треугольными, квадратными и шестиугольными порами. Все они оказались одинаково подходящими для восстановления костей.
Исследование было выполнено по госзаданию Минобрнауки (проект № FWES–2021–0025) и получило поддержку Российского научного фонда (проект № 23–64–10007) и Красноярского краевого фонда науки (грант № 20231107–06132). В перспективе ученые рассматривают использование разработки в области экологии: например, для изготовления биоразлагаемой упаковки.
Микроорганизмы, подавляющие активность различных птичьих патогенов, выделили исследователи из АлтГУ.
Фото: freepik / фотобанк Freepik
Бактерии против бактерий
Наконец, как насчет бактерий, способных стать эффективными борцами со своимих вредоносными собратьями? Именно такие микроорганизмы, подавляющие активность различных патогенов птиц, выделили исследователи из инжинирингового центра «Промбиотех» Алтайского государственного университета.
Штамм RCAM06423 вида Bacillus atrophaeus обнаружили в птичьей подстилке в одном из фермерских хозяйств. Оказалось, что эта разновидность бактерий эффективно подавляет развитие разнообразных болезнетворных грибков и микроорганизмов. При этом она устойчива к широкому диапазону температур и хорошо адаптируется к условиям среды. Изученные микроорганизмы сохраняют чувствительность к воздействию стандартных антибиотиков, поэтому их использование не грозит появлением штаммов, резистентных к препаратам. И это не все: данные бактерии также активно производят амилолитические ферменты, улучшающие переваривание птицами корма. Исследователи отмечают, что их находка может не только снизить зависимость хозяйств от антибиотиков, но и повысить продуктивность и безопасность агропромышленных производств.
Источники
Комментарии А.А. Пронченко
Комментарии А.С. Тугбаевой
НГТУ НЭТИ. Ученые НГТУ НЭТИ создали жидкий пылеподавитель (видео)
ЮУрГУ. Екатерина Больных. Впервые в России ученые ЮУрГУ восстановили памятник при помощи бактерий
УрФУ. Анна Маринович. Биологи УрФУ создали биопрепарат для роста сельскохозяйственных растений
ЦКП СКИФ (официальный сайт). Ученые СКИФ исследовали свойства синтезированных бактериями наноматериалов, перспективных для медицины и экологии
СФУ. Ученые СФУ создали костные имплантаты из отходов
«Наука.РФ». Штамм бактерий для замены антибиотиков создали в АлтГУ
Фото на главной странице: freepik / фотобанк Freepik
Фото на превью: Владимир Мартьянов / УрФУ
Источники изображений в тексте: Вероника Жарковская / пресс-служба НГТУ НЭТИ, из личного архива А.А. Пронченко, Александр Непомнящих / пресс-служба НГТУ НЭТИ, wirestock / фотобанк Freepik, Анастасия Мавренкова / УрФУ, Владимир Мартьянов / УрФУ, brgfx / фотобанк Freepik, freepik / фотобанк Freepik, freepik / фотобанк Freepik.